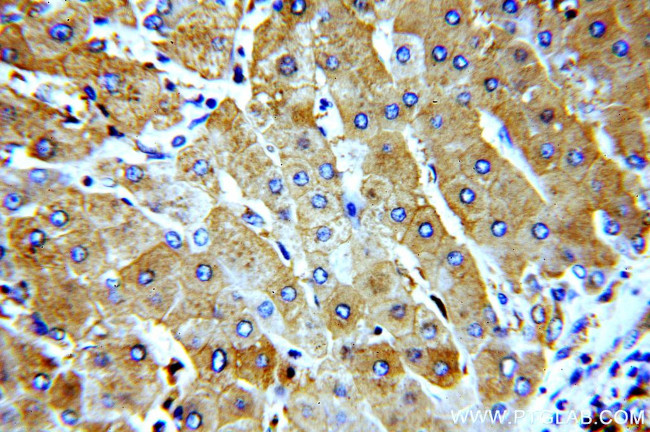
LTBR Antibody in Immunohistochemistry (Paraffin) (IHC (P))

Search
Proteintech
LTBR Polyclonal Antibody
{{$productOrderCtrl.translations['antibody.pdp.commerceCard.promotion.promotions']}}
{{$productOrderCtrl.translations['antibody.pdp.commerceCard.promotion.viewpromo']}}
{{$productOrderCtrl.translations['antibody.pdp.commerceCard.promotion.promocode']}}: {{promo.promoCode}} {{promo.promoTitle}} {{promo.promoDescription}}. {{$productOrderCtrl.translations['antibody.pdp.commerceCard.promotion.learnmore']}}
产品信息
20331-1-AP
种属反应
已发表种属
宿主/亚型
分类
类型
抗原
偶联物
形式
浓度
规格
纯化类型
保存液
内含物
保存条件
运输条件
产品详细信息
Immunogen sequence: KSHPSLCRK LGSLLKRRPQ GEGPNPVAGS WEPPKAHPYF PDLVQPLLPI SGDVSPVSTG LPAAPVLEAG VPQQQSPLDL TREPQLEPGE QSQVAHGTNG IHVTGGSMTI TGNIYIYNGP VLGGPPGPGD LPATPEPPYP IPEEGDPGPP GLSTPHQEDG KAWHLAETEH CGATPSNRGP RNQFITHD (249-435 aa encoded by BC026262)
靶标信息
The protein encoded by this gene is a member of the tumor necrosis factor (TNF) family of receptors. It is expressed on the surface of most cell types, including cells of epithelial and myeloid lineages, but not on T and B lymphocytes. The protein specifically binds the lymphotoxin membrane form (a complex of lymphotoxin-alpha and lymphtoxin-beta). The encoded protein and its ligand play a role in the development and organization of lymphoid tissue and tranformed cells. Activation of the encoded protein can trigger apoptosis.
仅用于科研。不用于诊断过程。未经明确授权不得转售。
生物信息学
蛋白别名: LT beta-R; LT-beta receptor; lymphotoxin B receptor; lymphotoxin beta receptor (TNFR superfamily, member 3); Lymphotoxin-beta receptor; TNF receptor-related protein; TNF-RIII; TNFR-III; Tumor necrosis factor C receptor; Tumor necrosis factor receptor 2-related protein; Tumor necrosis factor receptor superfamily member 3; tumor necrosis factor receptor superfamily, member 3; Tumor necrosis factor receptor type III; unnamed protein product
基因别名: AI256028; CD18; D12S370; LT-BETA-R; Ltar; LTbetaR; LTBR; TNF-R-III; Tnfbr; TNFCR; TNFR-RP; TNFR2-RP; TNFR3; TNFRrp; TNFRSF3
UniProt ID: (Human) P36941, (Mouse) P50284
Entrez Gene ID: (Human) 4055, (Mouse) 17000